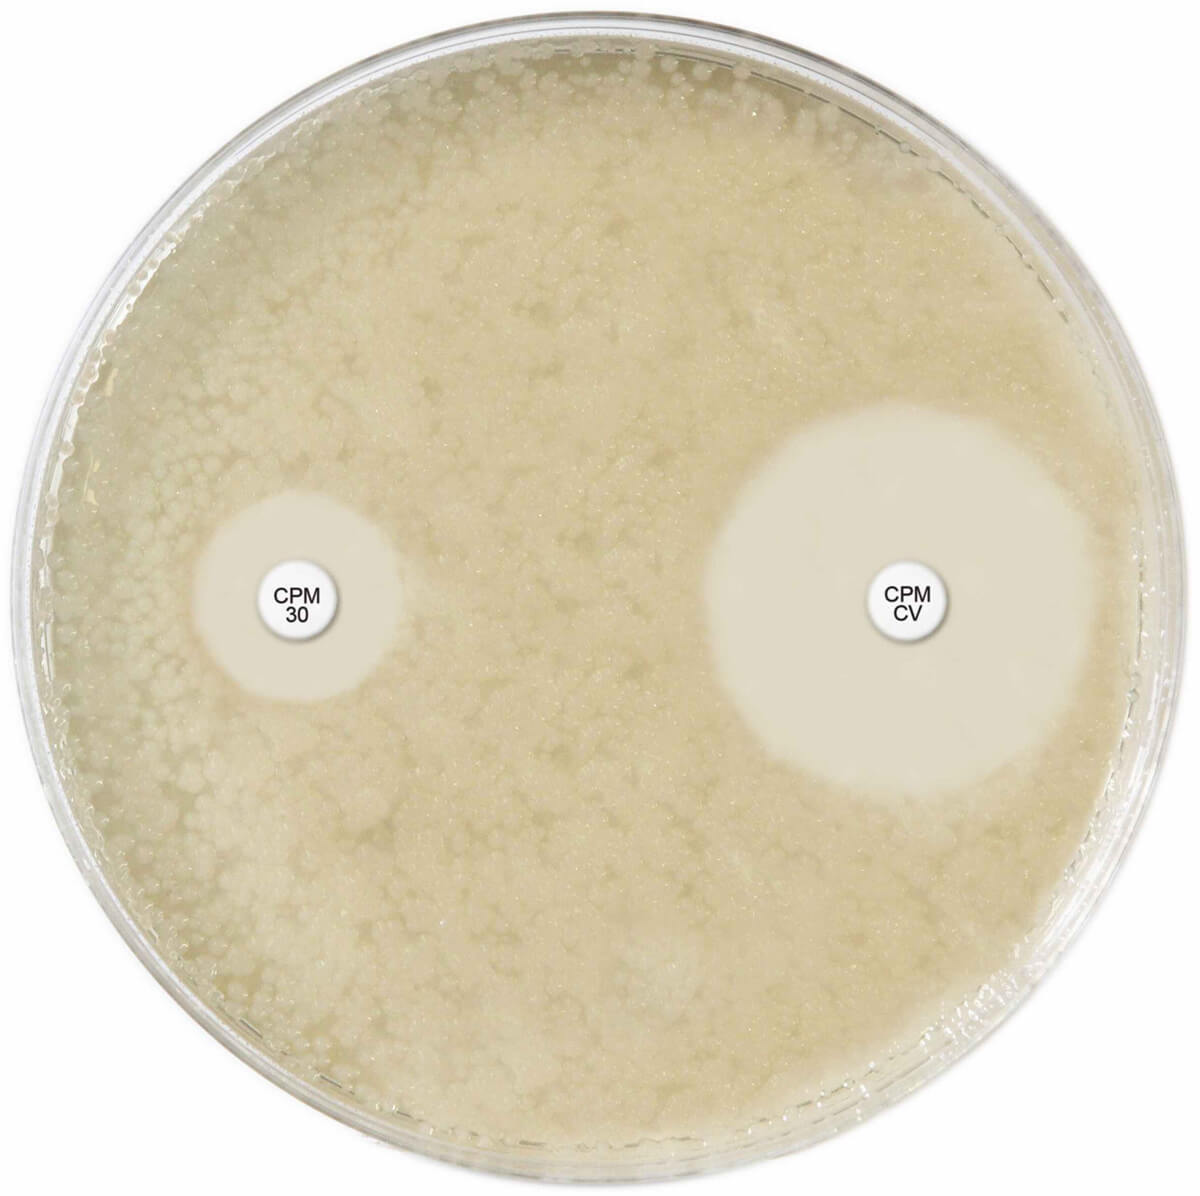

Über das Produkt
Antibiotika-Empfindlichkeitstestung zum Nachweis von ESßL-Produzenten.
- Cefepim 30 µg (3 x)
- Cefepim 30 µg + Clavulansäure 10 µg (3 x)
Cefepim ESßL - Set D63C

Antibiotika-Empfindlichkeitstestung zum Nachweis von ESßL-Produzenten.